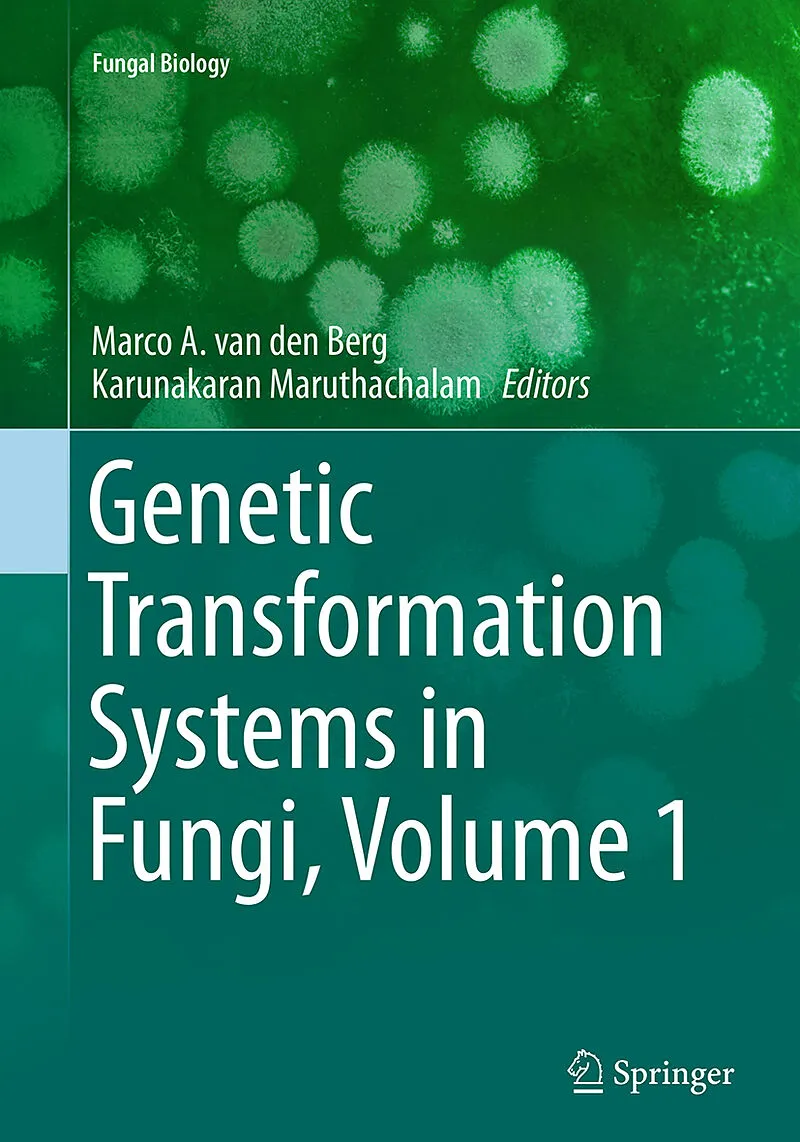

Beschreibung
Several different transformation techniques have been developed over the years and readily shown to be decisive methods in fungal biotechnology. This book will cover the basics behind the most commonly used transformation methods, as well as associated tools ...
Several different transformation techniques have been developed over the years and readily shown to be decisive methods in fungal biotechnology. This book will cover the basics behind the most commonly used transformation methods, as well as associated tools and techniques. Each chapter will provide protocols along with examples used in laboratories worldwide.
Not only will this text provide a detailed background on applications in industrial and pharmaceutical relevant microbes, but also the importance of fungal pathogens in agricultural production ( Phytophthora and Botrytis ) and mammalian infection ( Penicillium marneffei and Candida ). Genetic Transformation Systems in Fungi, Volume 1 provides in-depth coverage of how the transformation of DNA is used to understand the genetic basis behind these fungal traits.
The most comprehensive book on fungal transformation methods The best protocols to be applied in your lab Includes the latest tools and techniques
Autorentext
Marco A. van den Berg, PhD
Principal Scientist Applied Biochemistry and Screening
DSM Biotechnology Center
Delft, The Netherlands
Karunakaran Maruthachalam, PhD
Current: Research Scientist
Global Marker Technology Lab, DuPont-Pioneer
DuPont Knowledge Center
Andhra Pradesh, India
Previous: Molecular Biologist
California Seed and Plant Labs
Pleasant Grove, CA, USA
Inhalt
Fungal Transformation: From Protoplasts to Targeted Recombination Systems.- Protoplast Transformation for Genome Manipulation in Fungi.- Trichoderma **** Transformation Methods. - Transformation of **** Mucor circinelloides f. lusitanicus Protoplasts.- Transformation of Saccharomyces cerevisiae : **** Spheroplast Method. - Electroporation Mediated DNA Transformation of Filamentous Fungi. - Chemical Transformation of **** Candida albicans .- Electroporation of Pichia pastoris.- Insertional Mutagenesis of the Flavinogenic Yeast Candida famata (Candida flareli ). - Biolistic Transformation for Delivering DNA into the Mitochondria. **- ** Bolistic Transformation of Candida glabrata for Homoplasmic Mitochondrial Genome Transformants. **- ** Use of the Biolistic Particle Delivery System to Transform Fungal Genomes.- Transformation of Zygomycete Mortierella alpina Using Biolistic Particle Bombardment.- ** **** Agrobacterium tumefaciens- Mediated Transformation **.- ** Agrobacterium tumefaciens -Mediated Transformation of Pucciniomycotina Red Yeasts.- Glass-bead and Agrobacterium-mediated Genetic Transformation of Fusarium oxysporum .- High Efficiency DNA Transformation of Saccharomyces cerevisiae with the LiAc/SS-DNA/PEG Method.- Transformation of Intact Cells of Saccharomyces cerevisiae : Lithium Methods and Possible Underlying Mechanism.- Transformation of Lithium Acetate-treated Neurospora crassa.- Application of Novel Polymeric Carrier of Plasmid DNA for Transformation of Yeast Cells.- Transformation of Fungi Using Shock Waves.- Pathways and Mechanisms of Yeast Competence: A New Frontier of Yeast Genetics.- Evaluation of Competence Phenomenon of Yeast Saccharomyces cerevisiae by Lipophilic Cations Accumulation and FT-IR Spectroscopy. Relation of Competence to Cell Cycle.- **** Recombination andGene Targeting in Neurospora.- Efficient Generation of Aspergillus niger Knock Out strains by Combining NHEJ Mutants and a Split Marker Approach.- REMI in Molecular Fungal Biology.- TALEN-Based Genome Editing in Yeast.